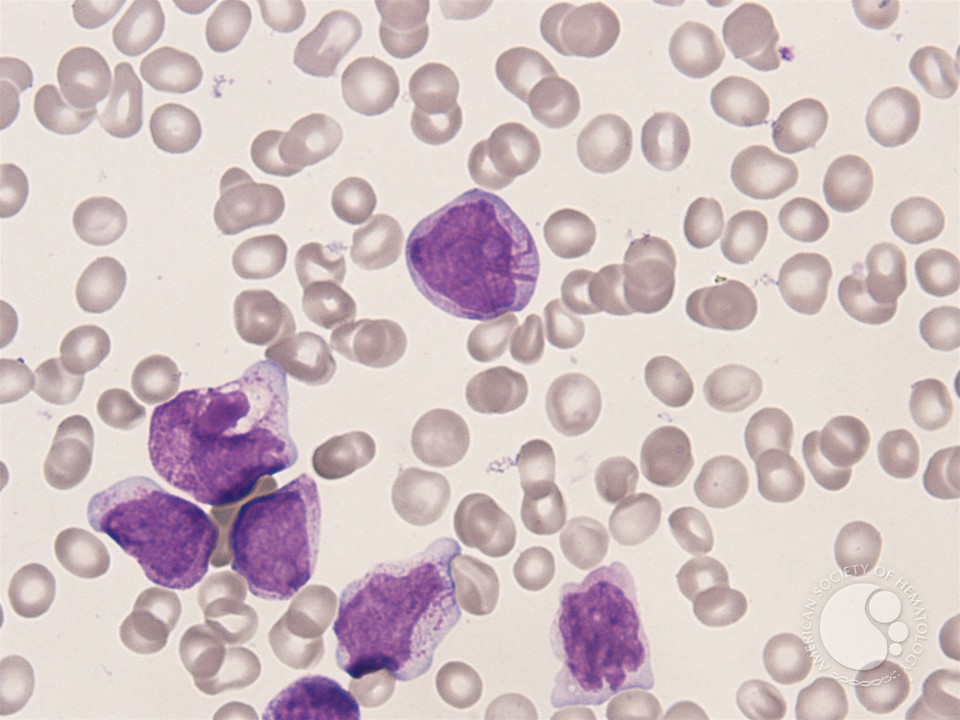

1/91
Looks like no tags are added yet.
Name | Mastery | Learn | Test | Matching | Spaced | Call with Kai |
|---|
No analytics yet
Send a link to your students to track their progress

pt w/ 1 month diarrhea, abd cramps, nausea, night sweats, nontender lympadenopathy, arthralgias, weight loss. pink, oval lesions (see pic) on upper chest, neck, face at the beginning of illness but have resolved.
HIV

2 weeks fever, dry cough, fatigue. went spelunking in central ameriaca recenmtly. cxr shows bilateral alveolar opacities & hilar lymphadenopathy
histoplasma capsulatum (mld form)


smudge cells (pathognomonic for CLL)

erythematous, tender nodules
hx cave diving, chicken farming
histoplasmosis
noncaseating granulomas on LN biopsy

cheeks, chest → abdomen, back, extremeties
fever, runny nose
chicken pox (varicella zoster)
auer rods → AML

firm, domed papule with central umbilication
molluscum contagiosum

collier sign/bilateral eyelid retraction
also w/ light-near dissociation (pupils reactive to accommodation but not light), limitation of upward gaze
parinaud syndrom/dorsal midbrain
pinealoma in kids

dyspnea, hypocia, reticulonodular opacities
hiv+
pneuocystis pnuemonia
tx with trimeth-sulfa

dry, erythematous, sharply-demarcated rash
diarrhea, depressive symptoms
pellagra (niacin/b3 deficiency)

small (<2cm) round lucency with sclerotic margin
pain worse at night, improves with nsaids
spinal osteoid osteoma - unmineralized osteoid that produces prostaglandins

small (<2cm) round lucency with sclerotic margin
pain worse at night, improves with nsaids
osteoid osteoma - unmineralized osteoid that produces prostaglandins

small, pruritic, tender papulopustules
does not resolve with tmp-smx
hot tub folliculitis (pseudomonas)

hx hip fracture, unsteadiness, now with progressive confusion, generalized weakness for several days
acute subdural hematoma caused by tearing of the bridging veins


fell down stairs, weakness of elbow extension & wrist flexion
decreased pain sensation in index & middle fingers
typically occurs with forced flexion of cervical spine (ie, falling onto flexed neck) → single facet disloicated, radiculopathy
this case is c7 radiculopathy


2-month hx, resolved and recurred, no pain/pruritis/etc
epidermal inclusion cyst


sudden onset of chest & neck pain prior to syncopal episode
dx?
acute aortic dissection
next step = ct angiography of aorta

angiosarcoma from radiation for breast cancer

cutaneous sporotrichosis
tx with antifungals

lichen planus
tx with steroids

14 y/o boy, knee pain after tripping and falling on wrestling mat
fixed, hard lesions palpated above and below the knee; cortices are contiguous with cortex of surrounding bone
osteochondroma


ewing sarcoma


osteosarcoma
ill-defined lesion with aggressice periosteal reaction
nontender groin bulge below inguinal ligament
femoral hernia
SURGICAL CORRECTION.

pneumoperitoneum (subdiaphragmatic free air)
→ perforated peptic ulcer

difficulty taking steps, unsteady
normal pressure hydrocephalus
tx: ventriculoperitoneal shunt

skiing accident, hip ROM limited, right leg shortened & internally rotated
posterior hip dislocation (posterior & inferior displacement of femoral head)

18 month old boy playing with cousin, sudden shortness of breath and wheezing
unilateral lung hyperinflation → foreign body aspiration


pregnant pt w/ no prenatal care presents with maculopapular rash involving trunk, extremities, palms/soles
secondary syphilis
usually begins in skin-cleavage lines of the trunk before migrating on

widening of the wrists due to rickets (vit d deficiency)

20yo man w/ 12 hrs increasing fever & confusion. never seen dr. no meds, 104F, delirious, diffuse rash over body
neisseria meningitidis
16-23yrs most likely serotype B (vs for it during those ages)
tx w/ ceftriaxone

21 yo with 3day hx vomiting & malaise, 6day hx of abd cramping. 1 week ago had medically-induced abortion. acutely ill-appearing, fever, elevated pulse, low bp. 1+ pitting edema
gram + rods → clostridium sordellii
produce lethal toxin & hemorrhagic toxin → toxic shock, nec fasciitis


1day hx fever & erythema of extremity. overnight it worsens, increasingly severe pain hx of partial masectomy & radiation therapy. had edema that side since. bright red, well-demarcated area extremely sensitive to the touch
erysipelas, usually group a strep (strep pyogenes)
rf: edema, lympedema
tx w/ regimen coverin staph & strep (cephalexin, doxy, clinda)


10hr history of shortness of breath, sharp, retrosternal chest pain radiating to neck and left shoulder, worse with movement/swallowing. also 1 week hx fever, malaise, myalgia, diarrhea, cough, scratchy sore throat
myopericarditis
ecg can show diffuse st segment elevation & pr segment depression
next step: echo

sudden onset of severe pain & light intolerance. no hx of trauma, no meds, no allergies. mild injection of conjuctiva & mild clouding.
anterior uveitis/iritis

narrowing and stricture of terminal ileum (crohn dz)

seborrheic keratosis

72yo with 4month hx leg swelling & increased abdominal girth. 2-year hx progressive sob. was a sandblaster.
silicosis
give o2

3m hx enlarging painful ulcer, decreased sensation over feet, htn, cad, hld
venous stasis ulcer

hx anorexia nervosa, passed out on way to bathroom at home
U waves after t waves (v2-3 best)
hypokalemia


7 year hx crohns w/ 2 months of intermittent fever, nonpreoductive cough, night sweats, & fatigue. on immunotherapy. cxr showed lingular & rll infiltrates. tx with abx → no improvement. spent time in southwest usa several months ago.
coccidoides (fungus), tx w/ fluconazole
15mo girl w/ 1-week hx URI, fever. minimal movement on pneumatic otoscopy.
acute otitis media


hx chronic/reccurrent ear infections
retraction pocket of tympanic membrane (pulled into middle ear)


12yo girl with thigh pain for 2 months, worsening in past 10 days with a low fever for 1 week. what is it and what is the most consistent natural history of this disease?
osteosarcoma, metastasis to the lungs. high mortality rate, even with surgical resection, because small undetectable cells may have already metastasized.



27yo man w/hiv; 10-day hx of fever, chills, malaise, yellow sputum. CD4 = 24, high viral load.
broad-based budding, similar size as RBC
blastomyces dermatitidis
endemic to missi/ohio river valleys.
tx with amphotericin b or azoles

from lung, hiv+
pneumocystis cyst

4wks after cardiac cath, comes in for 3-days of rash over knees. creatinine 1.6 immediatly after procedure, now 3.5. urinalysis shows many wbc and no casts.
livedo reticularis with atheroembolic renal disease

1yr hx of enlarging painless lesion. sometimes bleeds. no hx or other abnormalities
basal cell carcinoma
on face → mohs micrographic surgery (others could be tx with excision, electrodessication & curretage, or topical imiquimod)

52yo w/ 5-day hx of 100F & productive cough that is difficult to cough up. had similar sx twice yearly over the past 15 years, resolve with abx. no hx. pulse ox 94%. increased expiratory phase, rhonchi, faint wheezes bilaterally
bronchiectasis - irreversible

64yo, hx smoking, drinks 2 martinis daily, with 6month hx of midepigastric pain with eating & weight loss. telangiectasias over chest
chronic pancreatitis (shows calcification)

asymptomatic
2nd degree av block type 1
just observe if no sx

2-yr hx of easy sunburns (after 15 min) & redness of both eyes outside. what is he at risk for?
xeroderma pigmentosum - ar defect in nucleotide excision repair needed to combat UV light damage → premature photoaging of skin, freckling, solar lentigines, photophobia, ealy ca
squamous cell carcinoma

solar lentigo

47 yo man, elevated liver enzymes, fatigue
small vesicles & erosion on both hands. prior lesions healed w/ scarring & hyperpigmentation
porphorya cutanea tarda
assocaied with chronic hepatitis c

kayser-flescher ring (wilson disease)

actinic keratoses
precursor to scc

38F dry cough & malaise for 2 months
sarcoidosis (bilateral hilar adenopathy)
noncaseating granulamatous inflammation

tinea vesicolor
risk w/ HIV+ status

progressively worsening dyspnea over 2 days, former smoker
copd hyperinflation & acute exacerbation

liver bx
cirrhosis on histology

60y man with 2 months fatigue & 15lb unintentional weight loss over 6 months. temp 100.4, pulse 110, cervical & axillary lymphadenopathy, pallor, hgb 9.5.
dx & next step?
hodgkin lymphoma - germinal b cell lymphoma
reed-sternberg cell on biopsy (2 nucleoli in separate nuclear lobes), owl’s eye appearance
get a pet scan


senile purpura, due to perivascular connective tissue atrophy

35 yo woman w/ multiple painful oral ulcers, hx anterior uveitis, genital lesions, scattered hyperpigmented lesions, and tender, indurated areas on legs.
dx? what is the image of?
behcet disease
pathergy → exaggerated ulcerating skin response following minor inuries (eg needlestick)


35 yo woman w/ multiple painful oral ulcers (pic), hx anterior uveitis, genital lesions, scattered hyperpigmented lesions, and tender, indurated areas on legs.
dx?

22yo with new generalized tonic-clonic seizure, 3-week hx progressive headaches, fever, nasal congestion, & rhinorrhea. HIV -.
brain abscess
likely staph a, viridians strep, or anaerobes

35M hx several months of skin lesions, small papules → increased size, no pain or pruritis. plumber (kneels frequently).
plaque psoriasis

increased fatigue, hx of aortic valve replacement
schistocytes


malodorous vaginal discharge
clue cells in bacterial vaginosis (squamous epithelial cells with adherent bacteria)

white “curd-like” discharge in vulva
vulvovaginal candidiasis hyphae on microscopy

vulvovaginal pruritis & malodorous, green discharge
trichomonas (flagellated protozoa)

ectopic pregnancy on doppler us

35wks, SROM of bright red fluid. what is it, what category, and what does it likely mean?
sinusoidal FHT - smooth, wave-like oscuillation with fixed amplitude & frequency
category III
severe fetal anemia → fetal blood loss (ie vasa precia)
urgent c section.

48F 1 day fever & skin rash. hx serious ovarian carcinoma with recent discovery of liver metastasis. recieved chemo prior & new 1 week ago. several indurated, nontender macules & pustules on the trunk; some lesions became gangrenous ulcers. cbc hgb 8.8, plt 102k, leuko 2.8k
ecthyma gangrenosum caused by pseudomonas; pt has gram - bacteremia


40M w. 1 month progressively worsening burning & tingling in hands & feet. patchy hyper/hypo pigmentation on the neck. hyperkeratoses & scaling on palms & soles, increased sensitivity to pinprick & light touch on fingers/toes, weak plant/dorsiflexion at the ankle, weak interossei & wrist flexors & extensors. DTRs 1+. works on fences. cbc shows pancytopenia & elevated AST & ALT.
arsenic poisoning


nocardia


23F progressive low back pain & stiffness over years, worsened recently. pain relieved with activity and ibuprofen. on exam, reduced forward flexion of lumbar spine & tenderness over lumbosacral area.
what does the xray show? what is most likely to diagnose this? what is the likely dx?
bamboo spine (fusion of the vertebral bodies & discs)
x-ray of sacroiliac joints
ankylosing spondylitis

chronic intermittent nonbloody diarrhea, hx drinking untreated freshwater
giardiasis

39wks, contractions, progressive cer dialation. what does this show?
normal labor progression - reassuring ft (moderate variability accelerations, no decels)

32M 3-month hx painless rash over arms, weight loss
kaposi sarcoma

2-days of red, severly painful lesion on forearm. felt a sting when putting the shirt on
brown recluse
will form black eschar at center of wound

difficulty conceiving.
female factor infertility - has hx of PID, there is no contrast in the tubes, theyre likely scarred

5M w/ 2 day hx of itchy rash on forearm, cheek, & ankle. new bath soap, recent picnic, cats & dogs at home.
poison ivy (delayed type iv hypersensitivity reaction)

what is she at greatest risk for during pregnancy?
preterm labor

kid brought in during family vacation in florida for 3 days of itchy, burning rash. no known exposures. clear 1-2mm vesicles resembling water droplets that rupture easily on palpation.
miliaria crystallina (heat rash)
avoid heat, keep the skin cool. will resolve spontaneously

16F w/ 5 days of pruritic lesion on back w/ multiple new lesions following lines of tension. erythematous macules with minimal scaling. no palms/soles. fever, headache, and malaise abt 1 week ago.
pityriasis rosea


72F with this ecg. what do you do next>
defibrillation


2F, 4 days ago developed vesicular rash on left side of neck that spread to upper back. given tmp-sfx but now its erosions covered with crusts. tender cervical lns palpated.
eczema herpeticum


hiv+, sometimes missed prophy, 2 weeks of headaches and confusion. friends say he’s aggressive and suspicious, which is not normal for him.
toxoplasma, can reactivate if cd4 <100
could be tx/prevented with tmp-smx


23M w/ rash & diarrhea. what is it & what is the likely underlying association?
erythema nodosum, inflammatory bowel disease